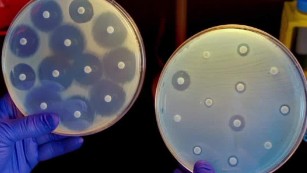

Suốt trong tuần qua, sự kiện “siêu vi khuẩn” kháng thuốc kháng sinh (Antibiotic-Resistant ‘Superbug’) đầu tiên được phát hiện ở Hoa Kỳ làm dấy lên nỗi lo ngại cho các nhà chuyên môn cũng như giới khoa học khi nó kháng với nhiều thuốc kháng sinh, thậm chí với cả Colistin được coi là liệu pháp cuối cùng khi mà các thuốc kháng sinh khác thất bại.
Siêu vi khuẩn kháng kháng sinh đầu tiên được phát hiện tại Hoa Kỳ (First Antibiotic-resistant Superbug Found in US)
Ngày 26/05/2016. VOA News. Hoa Kỳ có thể đang trên đường dẫn tới một kỷ nguyên hậu kháng sinh (post-antibiotics era), khi nhiều người hơn sẽ tử vong do các bệnh nhiễm khuẩn thông thường. Theo một nghiên cứu xuất bản vào hôm thứ năm, các nhà nghiên cứu của Bộ Quốc phòng (Defense Department) Hoa Kỳ xác nhận việc khám phá ra vi khuẩn kháng kháng sinh trong nước tiểu của một phụ nữ bang Pennylvania tại một phòng khám quân đội tháng trước. TS. Tom Frieden-Giám đốc Trung tâm kiểm soát và phòng ngừa dịch bệnh (CDC) Hoa Kỳ cho rằng khám phá này có thể đồng nghĩa với việc chúng ta đang ở “cuối con đường” (end of the road) kháng sinh mà chúng ta đã phụ thuộc vào nó trong nhiều năm qua, Frieden và các quan chức y tế công cộng khác từ lâu đã cảnh báo sự lạm dụng kháng sinh giúp hình thành thứ mà chúng ta đã biết đến là “siêu vi khuẩn” (superbugs). Ông cho biết người phụ nữ tại bang Pennsylvania bị nhiễm trùng đường tiết niệu kháng với “tất cả các loại kháng sinh, kể cả loại sử dụng gần đây nhất là colistin một loại kháng sinh cũ, nó là loạiduy nhất được gọi là 'vi khuẩn ác mộng' (nightmare bacteria)”. Họ vi khuẩn này bao gồm Enterobacteriaceae kháng Carbapenem (Carbapenem-Resistant Enterobacteriaceae_CRE) mà CDC cho rằng là vấn nạn y tế công cộng cấp bách nhất của quốc gia.
Tủ thuốc ‘trống rỗng’ (Medicine cabinet ‘empty’)
Frieden cho rằng mối lo ngại không chỉ là đấu tranh chống lại “những bệnh nhiễm trùng xấu như viêm phổi, nhiễm trùng đường tiết niệu” mà còn là hàng nghìn bệnh nhân nằm trong tầm đặc biệt nguy hiểm như “600.000 người dân Mỹ một năm cần được điều trị ung thư, những người mà chúng ta chỉ giả định sẽ điều trị những bệnh nhiễm trùng cho họ”. Ông nói, đối với một số người trong số này thì“tủ thuốc là trống rỗng” (the medicine cabinet is empty). Các loại kháng sinh đã cách mạng hóa ngành dược trong giữa thế kỷ 20 làm cho các ca phẫu thuật an toàn hơn, nếu kháng sinh không thể chữa trị các nhiễm trùng thì con người có thể chết vì các vết thương nhỏ hoặc một ca tiểu phẫu.

Một nhà vi trùng học đọc tấm bảng kiểm tra tình trạng kháng của một vi-rút với một loại kháng sinh trong một phòng thí nghiệm tại US CDC, Atlanta, Georgia, ngày 25/11/2013
Sử dụng không hợp lý (Improper use)
Vi khuẩn đang tiến hóa không ngừng vì vậy những loài sống sót khỏi những loại thuốc được điều chế để giết chúng lại tiếp tục sinh sôi, điều đó là bình thường và chính bản thân kháng sinh không gây ra tình trạng kháng thuốc mà việc sử dụng kháng sinh không hợp lý là một trong những nguyên nhân chính gây ra sự phát triển các vi khuẩn kháng thuốc kháng sinh. Điều khiến mọi vấn đề trở nên tồi tệ hơn là phần lớn mọi người không hiểu kháng sinh chỉ có hiệu quả chống lại nhiễm trùng vi khuẩn, không phải dành cho các vi-rút như cảm cúm hoặc cảm lạnh. US CDC cho biết hơn 2 triệu người bị nhiễm bởi các mầm bệnh kháng thuốc hàng năm và 23.000 người tử vong vì chính sự nhiễm trùng của họ. Theo Tổ chức Y tế thế giới (WHO), hầu như các ca tiêu chảy (diarrhea), nhiễm trùng huyết (sepsis), viêm phổi (pneumonia) và bệnh lậu (gonorrhea) đang lây nhiễm thêm trên hàng triệu người trên toàn cầu.

Ngày mà các bác sĩ lo sợ từ lâu đã đến (A day long-feared by doctors has arrived)
Ngày 29/5/2016. John Hayward. Ngày mà các bác sĩ lo sợ từ lâu đã đến: một bệnh nhân tại Hoa Kỳ đã nhiễm một chủng vi khuẩn dường như hoàn toàn kháng với các loại thuốc kháng sinh (A day long-feared by doctors has arrived: A patient in the United States infected by a strain of bacteria that appears completely resistant to antibiotics). Trước khi khám phá ra tầm quan trọng của sự phát triển này, điều quan trọng phải kể đến là bệnh nhân trong trường hợp này còn sống và đã được cho xuất viện dù nghiên cứu được báo Washington Post đưa tin chưa rõ ràng về những chi tiết về tình trạng bệnh của người phụ nữ này. Cô đã được miêu tả là một phụ nữ Pennsylvania 49 tuổi, trong nước tiểu có chứa một chủng vi khuẩn E. coli kháng lại thuốc colistin, “loại thuốc kháng sinh cứu cánh cuối cùng” (antibiotic of last resort). Cô đã được điều trị tại một cơ sở quân đội ngoại trú tại bang Pennsylvania với sự tham gia của Bộ Quốc Phòng và Trung tâm Quân y Quốc gia (National Military Medical Center) Walter Reed. CNN đưa tin thêm rằng bệnh nhân này không hề du lịch ra khỏi Hoa Kỳ trong vòng 5 tháng qua nhưng các bác sĩ không tìm ra nguyên nhân làm thế nào mà vi khuẩn có thể xâm nhập vào cơ thể cô. Tuy nhiên, các nhà nghiên cứu xem bệnh nhân này nhưngười báo hiệu ngày diệt vong. Theo lời trích dẫn trên báo Washington Post từ các chuyên gia-một trong số đó là Giám đốc CDC, Bác sĩ Tom Frieden cho biết tình trạng bệnh của người phụ nữ này “báo hiệu tình trạng khẩn cấp của một vi khuẩn thực sự kháng tất cả loại thuốc” (heralds the emergency of a truly pan-drug resistant bacteria), một “vi khuẩn ác mộng” (nightmare bacteria), một “siêu vi khuẩn” (superbug) và có lẽ là “đoạn cuối con đường của các loại thuốc kháng sinh” (end of the road for antibiotics).

Chủng E. coli kháng thuốc kháng sinh được phát hiện (Janice Carr/CDC via AP)
Một chủng vi khuẩn kháng colistin nguy hiểm hơn trước đó đã được phát hiện ở những con lợn và một số người tại Trung Quốc, Canada và châu Âu. CNN đưa tin rằng Bộ Nông nghiệp Hoa Kỳ(USDA) đã tìm thấy một mẫu E. coli kháng thuốc trong một mẫu ruột của lợn và đã và đang lần theo dấu vết con lợn đó đến từ trang trại nào. Ngoài ra, người ta cũng cho biết rằng kháng sinh colistin cứu cánh cuối cùng đang được sử dụng thường xuyên hơn dù nó có thể gây ra các biến chứng bao gồm cả tổn thương thận. Trong khi gen kháng thuốc lan sang nhiều vi khuẩn hơn, con siêu vi khuẩn này sẽ bắt đầu giành chiến thắng một cuộc chạy đua với các loại thuốc kháng sinh Trường hợp khiến các bác sĩ hoảng sợ này bản thân nó không được coi là một chủng đặc biệt nguy hiểm vì bệnh nhân đã hồi phục và không có chiều hướng cho thấy chủng E. coli của người này chuyển thành một dịch bệnh. Thay vào đó, nỗi sợ hãi là các gen kháng kháng sinh sẽ bắt đầu nhân rộng vào trong các vi khuẩn khác nguy hiểm hơn. Một trong số những chủng mạnh nhất đã từng kháng với gần như mọi thứ ngoại trừ colistin, CNN dẫn chứng các thống kê của CDC rằng ít nhất 2 triệu người Mỹ mỗi năm bị nhiễm các vi khuẩn có khả năng kháng thuốc cao và ít nhất 23.000 trong số này đã tử vong vì các bệnh nhiễm trùng của họ, sự tiến hóa của một “siêu vi khuẩn” thực sự sẽ làm con số này tăng lên rất nhiều. Reuters đưa ra một số yếu tố đóng góp vào sự nổi lên của siêu vi khuẩn này bao gồm kê quá liều thuốc kháng sinh bởi các bác sĩ (over-prescription of antibiotics by doctors), sử dụng rộng rãi chúng trong các sản phẩm thực phẩm (their widespread use in food products) và sự không sẵn lòng của các công ty dược trong việc đầu tư các nguồn lực quy mô lớn vào việc phát triển các liệu pháp điều trị mới vì kháng sinh không có lợi nhuận bằng các sản phẩm khác (reluctance of pharmaceutical companies to put extensive resources into developing new treatments because antibiotics are not as profitable as other products). Về ý thứ 3 ở trên, Reuters đưa tin rằng hàng chục nhà sản xuất thuốc và các công ty chẩn đoán đã “ký một bản tuyên bố kêu gọi những khích lệ mới từ các chính phủ trong việc hỗ trợ đầu tư phát triển các loại thuốc để đấu tranh với các siêu vi khuẩn kháng thuốc”. Giám đốc CDC Frieden đã cảnh báo rằng “chúng ta có thể đang ở trong một tình huống mà các bệnh nhân trong các đơn vị chăm sóc đặc biệt hoặc các bệnh nhân bị nhiễm trùng đường tiết niệu mà lại không có thuốc kháng sinh cho họ”. Thượng nghị sĩ bang Pennsylvania Robert Casey cũng được báo Washington Post trích lời khi mô tả rằng vi khuẩn kháng thuốc kháng sinh là một “vấn đề y tế công cộng cấp bách mà chúng ta phải tập trung xử lý mạnh tay” (urgent public health problem that we must focus on intensively). David Hun từ tổ chức phi lợi nhuận Pew Charitable Trust cho biết: “Điều này là vấn đề cực kỳ đáng báo động, thực tế phát hiện ra nó tại Hoa Kỳ xác nhận những nghi vấn khiến chúng ta phải hành động cấp bách hơn đối với trách nhiệm quản lý và giám sát kháng sinh cho hình thức kháng này”.
Siêu vi khuẩn nguy hiểm được tìm thấy lần đầu tiên ở một người phụ nữ Hoa Kỳ (A dreaded superbug found for the first time in a U.S. woman)
Ngày 27/05/2016. CNN Health. Một phụ nữ 49 tuổi bang Pennsylvania có biểu hiện nhiễm một loại vi khuẩn E.coli hiếm gặp, ca mắc đầu tiên của loại virus này tại Mỹ. Trường hợp này được phân tích chi tiết trong báo cáo của Bộ Quốc phòng Hoa Kỳ vào ngày thứ năm. Giám đốc US CDC, Tom Frieden thông báo về ca bệnh tại Câu lạc bộ Báo chí Quốc gia (National Press Club) tại Washington. Người phụ nữ đến khám tại phòng khám ở Pennsylvania, mẫu bệnh phẩm được đưa đến Trung tâm Y tế Quân đội quốc gia Water Reed và phát hiện ra vi khuẩn trong nước tiểu của cô. Chưa biết nguyên nhân nào vi khuẩn này nhiễm vào cơ thể người phụ nữ, cô đã không đi ra khỏi Hoa Kỳ trong 5 tháng qua, ngay lập tức US CDC và Bộ Y tế Pennsylvania huy động lực lượng điều tra ca bệnh và theo dõi các đối tượng mà bệnh nhân tiếp xúc trong thời gian vừa rồi để xem liệu siêu vi khuẩn này có thể lây lan hay không. Theo TS. Alex Kallen, nhân viên y tế CDC, người phụ nữ được điều trị và giảm các triệu chứng và không có các vấn đề y tế khác liên quan đến siêu vi khuẩn mà chúng ta biết đến. CDC cho rằng họ đang tìm kiếm các ca bệnh có khả năng nhiễm khác tại các cơ sở y tế có bệnh nhân đến khám, vi khuẩn được xác định ở các bệnh lây nhiễm khác bên ngoài Hoa Kỳ mà các bác sĩ đã chứng kiến các ca bệnh tại châu Âu, Canada và Trung Quốc. Theo thông báo của Sở Y tế, USDA cũng phát hiện một chủng E.coli kháng colistin trong một mẫu bệnh phẩm ở ruột lợn và Bộ này đang cố gắng xác định các trang trại nuôi lợn để xem liệu có con nào bị ảnh hưởng hay không.

Chúng ta có thể bảo vệ thế giới tránh tình trạng kháng thuốc nếu chúng ta hành động ngay bây giờ, các chuyên gia cho biết
Theo Kallen, hai ca này được CDC miêu tả như là “dấu hiệu cảnh báo hơn là một thảm họa” (warning sign, more than a catastrophe). Mối quan tâm đó là các đặc điểm của vi khuẩn E.coli kháng Colistin đột biến hiếm gặp này có thể nhảy sang vi khuẩn khác mà chỉ đáp ứng Colistin, tạo ra một siêu vi khuẩn có khả năng không thể chấm dứt. Một báo cáo cho thấy rằng bệnh truyền nhiễm kháng thuốc kháng sinh có thể dẫn đến tử vong cho một nửa số lượng bệnh nhân bị lây nhiễm, kháng thuốc kháng sinh trở thành một vấn đề đang gia tăng tại quốc gia này, WHO cảnh báo rằng đó là một trong những mối đe dọa lớn nhất đối với sức khỏe toàn cầu hiện nay. Bác sĩ Frieden cảnh báo rằng mặc dù đây là ca mắc đầu tiên tại Hoa Kỳ, chúng ta sẽ chứng kiến nhiều loại siêu vi khuẩn như vậy trong tương lai gần. Ông Friden là người thường xuyên cảnh báo các bác sĩ chống việc lạm dụng các thuốc kháng sinh và ông kêu gọi các bác sĩ nghiên cứu các thuốc điều trị mới nhanh chóng. Theo CDC, mỗi năm tại Hoa Kỳ có ít nhất 2 triệu người bị lây nhiễm các loại vi khuẩn khác nhau mà có thể bị tiêu diệt với hâu hết các loại thuốc kháng sinh, trong đó ít nhất 23.000 người tử vong mỗi năm do bị nhiễm các loại vi khuẩn đó.
Các nhà khoa học lo sợ 'siêu vi khuẩn đáng sợ' (Scientists Fear Nightmare Bacteria)
Ngày 28/05/2016. VOA News. Tin tức trong tuần này về sự phát hiện của “siêu vi khuẩn” đang gây chú ý bởi nó giống như một loại vi khuẩn nhưng kháng với tất cả các loại thuốc kháng sinh, chưa từng xuất hiện trước đây tại Hoa Kỳ. Giám đốc US CDC, TS. Tom Frieden cho biết vi khuẩn mới này kháng với mọi thuốc kháng sinh trong nguồn thuốc của bác sĩ, kể cả Colistin là thuốc kháng sinh được lựa chọn cuối cùng cho các bác sĩ người Mỹ chiến đấu với virus mà ông Frieden gọi là “siêu vi khuẩn đáng sợ” (nightmare bacteria), mặc dù các tác dụng phụ độc hại của nó gồm có tổn thương gan. Thuốc kháng sinh này được biết đến từ những năm 1950, ngày càng được sử dụng bởi vì nó thường có hiệu quả đối với vi khuẩn kháng thuốc kháng sinh nhưng điều đó đã thay đổi vào tháng trước khi các bác sĩ tại bang Pennsylvania phát hiện một người phụ nữ mà họ đang điều trị bị nhiễm bởi một dạng của vi khuẩn E.coli, được biết là CRE chứa một gen kháng với colistin, Hiện tượng này xảy ra ở một số khu vực trên thế giới nhưng chưa từng có trước đây tại Hoa Kỳ. CDC cho biết trường hợp tồi tệ nhất có thế dẫn tới “tình trạng khẩn cấp vi khuẩn kháng thuốc” (emergence of truly pan-drug resistant bacteria)-các vi khuẩn sẽ không tiếp nhận bất cứ loại thuốc nào mà bác sĩ có thể áp dụng để chống lại chúng.

Vi khuẩn E. coli
Vai trò của vi khuẩn (Role in bacteria)
Thuốc kháng sinh được kê đơn để chống lại và tiêu diệt vi khuẩn xâm nhập ở một vài phương pháp khác nhau: chúng có thể tiêu diệt bức tường tế bào của vi khuẩn hoặc ngăn ngừa vi khuẩn gây tàn phá cho các tế bào hoặc chúng có thể gây cản trở vi khuẩn sinh sản, ngăn chặn bệnh lây lan. Thậm chí sau khi một một bênh nhân bị nhiễm bệnh được điều trị một đợt thuốc kháng sinh, hầu hết các ca bệnh một số lượng nhỏ vi khuẩn vẫn còn tồn tại, đây có thể là các sinh vật đột biến hoặc tiến hóa thành một hình dạng mà cho phép chúng tồn tại sau điều trị kháng sinh. Các cơ quan y tế Hoa Kỳ ước tính vi khuẩn kháng thuốc kháng sinh gây bệnh cho 2 triệu người Mỹ một năm, trong đó có 23.000 người tử vong. Herman Goossens, một giáo sư chuyên khoa vi trùng học ở trường Đại học Antwerp của Bỉ phát biểu trên VOA rằng khả năng đột biến của vi khuẩn tăng khi các bác sĩ kê đơn thuốc “như một ly cocktail” (a cocktail) nhiều loại thuốc kháng sinh để đối phó bệnh nhiễm trùng chưa xác định.

Cuộc sống tìm ra cách giải quyết (Life finds a way)
Việc “kê đơn thuốc quá liều” (overprescribing) làm tăng khả năng nhiễm vi khuẩn sẽ đột biến hoặc tiến hóa-thay đổi cấu trúc tế bào và gen làm cho vi khuẩn kháng với thuốc kháng sinh đang được sử dụng, khi vi khuẩn kháng thuốc tăng lên nhiều lần và lây lan sang các bệnh nhân khác, cuối cùng thuốc kháng sinh trở nên vô dụng. Goossenns nói rằng: “Tất cả đã sai, việc kê đơn thuốc phải thay đổi” (That's all wrong, this practice has to change), các nhà sản xuất dược phẩm đã chi một khoản tiền lớn về nghiên cứu nhằm mục tiêu tìm ra các thuốc kháng sinh mới và hiệu quả hơn và việc điều trị bệnh nhiễm trùng mới cũng đang được nghiên cứu. Tạp chí Nature báo cáo rằng các nhà nghiên cứu ở một số trường đại học của Hoa Kỳ đề nghị các virus có thể được sử dụng để tấn công vi khuẩn xâm nhập và cho biết virus chống vi khuẩn còn gọi là “thực khuẩn” (bacteriophages), đặc biệt có thể nhắm mục tiêu và tiêu diệt vi khuẩn. Các nhà nghiên cứu cho rằng khi virus bám vào bề mặt của vi khuẩn riêng biệt chúng cũng làm vô hiệu hóa kháng thuốc của vi khuẩn-trong thực tế làm thuốc cũ trở nên nới và hiệu quả trở lại.

Như vậy, mối nguy hiểm không phải chỉ vì một “superbugs” mà là cho cả một thế hệ thuốc kháng sinh, điều mà các bác sĩ lo ngại đã trở thành hiện hữu. Theo đó, hậu quả trước mắt là kháng thuốc kháng sinh làm bệnh ngày càng lâu khỏi và tiến triển nặng hơn, nguy cơ tử vong cao hơn đe dọa mạng sống của mỗi người và toàn xã hội. Từ trường hợp “superbugs” này, trước hết chúng ta thấy nhận thức về kháng thuốc của cộng đồng còn nhiều hạn chế từ thói quen tự mua thuốc của người dân dẫn đến tình trạng sử dụng kháng sinh tùy tiện, làm tăng sự kháng thuốc. Cùng với đó, tại các cơ sở điều trị việc sử dụng thuốc kháng khuẩn không thích hợp do dùng quá liều hoặc không đủ liều quy định hoặc điều trị bao vây, lạm dụng thuốc kháng sinh tạo cơ hội cho các vi khuẩn kháng thuốc xuất hiện. Đặc biệt là tình trạng sử dụng thuốc kháng khuẩn trong chăn nuôi đang được sử dụng khá rộng rãi nhằm thúc đẩy tăng trưởng và phòng ngừa bệnh tật cho vật nuôi không được kiểm soát hợp lý cũng dẫn đến vi khuẩn kháng thuốc ở người.